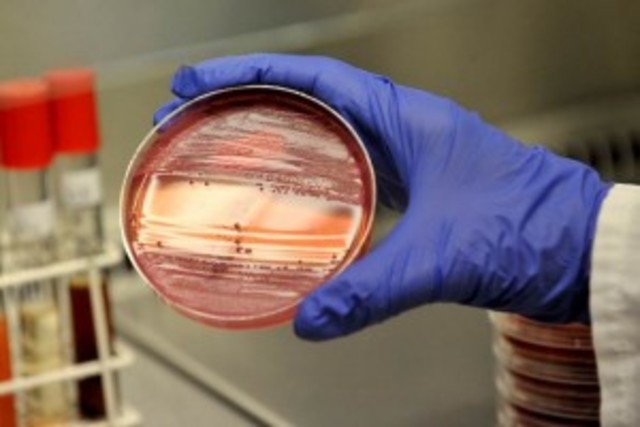
Método para reproducir bacterias en un medio de cultivo

-
En su libro Girolamo Frascatorius “De contagione et contagionis” (1546) habla de las enfermedades contagiosas se deben a “gérmenes vivos” que pasan de diversas maneras de un individuo a otro
-
El microscopio fue inventado por Zacharias Janssen en 1590. En 1665 aparece en la obra de William Harvey sobre la circulación sanguínea al mirar al microscopio los capilares sanguíneos, y Robert Hooke publicó su obra Micrographia.
-
Primero en describir y dibujar un microorganismo tomando como molde uno que encontró creciendo en la piel de la pasta de un libro
-
Robert Hooke usando microscopios compuestos, descubrio hongos filamentosos
-
Demostró que la generación espontánea no era aplicable a animales
-
Primero en observar bacterias o "animálculos" Se lo considera el descubridor del mundo microbiano.
-
DESCUBRIMIENTO DE LAS BACTERIAS
-
Edward Jenner invento la primera vacuna segura contra la viruela y estudia la resistencia a la viruela que presentaban ciertos grupos de población y comienza el desarrollo de técnicas de vacunación.
-
Hizo la primera prueba experimental de un agente biológico como causa de una enfermedad epidémica, que pudo demostrar que cierta enfermedad del gusano de seda
-
La familia Solanaceae es reconocida mundialmente por su importancia en términos de vegetales cultivables y el amplio rango de utilidad agronómica de sus especies, que incluyen al importante género Solanum (The International Solanaceae Genome Project, 2004)
-
La bacteria que causa el ántrax . El ántrax se diferencia de la mayoría de las bacterias en que existen en una forma inactiva (latente) del Estado llamado esporas.
-
René Dutrochet fue el primero en establecer que la célula era la unidad básica de la estructura.Mathias Schleiden llegaba a la conclusión de que todos los tejidos vegetales estaban formados por células.
-
demuestra q los microorganismos no se originan por generacion espontanea
-
Johan Friedrich Miescher. Biólogo suizo Aisló varias moléculas ricas en fosfatos, a las cuales llamó nucleínas , a partir del núcleo de los glóbulos blancos en 1869, y así preparó el camino para su identificación como los portadores de la información hereditaria, el ADN.
-
Investigó la morfología de las algas y los hongos, y analizó el origen bacteriológico de enfermedades infecciosas de las plantas y los animales.Descubrió la naturaleza y principales propiedades de las esporas bacterianas
-
Hoy conocida precisamente como tindalización, que evidenció la existencia de formas microbianas de reposo muy resistentes al calor
-
Koch ideo un método para reproducir bacterias en un medio de cultivo sólido hecho con gelatina, e introdujo el método de la placa para asegurar cultivos puros.
-
En 1880, comprueba que es posible protegerse de las enfermedades infecciosas mediante la inyección de gérmenes atenuados. Después de ensayos coronados exitosamente contra enfermedades animales, como el cólera de las gallinas, en 1885 aplica su tratamiento al joven Joseph Meister,
-
Koch descubre el germen de la tuberculosis.
-
Christian Gram desarrolla su método de tinción de bacterias.
-
La asepsia quirúrgica es la esterilización completa y la ausencia casi total de bacterias en un área. Es de fundamental importancia en la sala de operaciones. Es un proceso utilizado para prevenir la contaminación de microbios y endoesporas, antes, durante y después de una cirugía y utilizando materiales y técnicas esteriles.
-
Richard Petri introduce placas de petri en el uso de la microbiologia.
-
S. Winogradsky Fue el primero en desarrollar el concepto de quimiolitotrofía y de este modo revelar el papel esencial que los microorganismos juegan en los procesos geoquímicos
-
Reed descubre el primer virus humano
-
Descubre la cura para la sifilis
-
En 1911, Rous consiguió aislar tal virus de un tumor canceroso de un pollo; infectó con él a otros pollos, que desarrollaron el mismo tumor. Ello supuso la primera prueba de que los virus son capaces de producir tumores cancerosos.
-
Paul ehrlich descubre la cura para la sifilis
-
Morgan propugnador de la teoria de los genes.
-
Fleming descubre por accidente en una investigacion de gripe la penicilina
-
Max Delbruck y Salvador Luria. Herencia de las caraterísticas genéticas en bacterias.
-
Usando una enzima llamada papaína, rompió la inmuglobina de la sangre en partes, haciendo más fácil su estudio. También observó como la inmuglobina de la sangre reacciona con la superficie celular.
-
Se aprueba el uso de la primera vacuna producida mediante la ingenieria genetica (contra la hepatitis b en humanos)
-
Fulghum, Wiggins y Mullaney(26) señalan que las bacterias anaerobias se encuentran en proporciones que varían ampliamente, lo que sugiere que las condiciones de cultivo en la práctica endodóntica y las investigaciones hasta el momento no eran suficientemente sensibles para detectar todas las bacterias anaerobias en especímenes endodónticos.
-
Demostró que las arqueobacterias presentan una línea evolutiva diferente a las bacterias
-
Se sintetiza insulina por tecnicas de dna recombinante
-
se desarrolla una vacuna recombinante contra la hepatitis b
-
En 1983 el equipo del que forma parte describió e identificó lo que sería uno de los mayores descubrimientos de las últimas décadas del siglo XX: el virus VIH causante del sida, apenas poco después de que este síndrome fuera reconocido como una nueva entidad patológica
-
En 1985, mientras seguía trabajando en Cetus, desarrolló la técnica de la reacción en cadena de la polimerasa, (PCR en sus siglas en inglés)
-
Descubrimiento de arqueas marinas
-
Craig Venter ya presentó en 1999 una investigación que probaba que el organismo con menos genes que se conoce puede llegar a funcionar, en las condiciones ideales de laboratorio, con un número que puede oscilar entre 265 y 350.
-
El genoma de escherichea coli es secuenciado
-
Aparicion en asia de la gripe aviar producida por el suptipo H5n1
del virus influenza A que puede transmitirse al hombre
Looking for a timeline maker?
Create timelines for projects, roadmaps, history, lessons, legal cases, and stories with Timetoast. Timetoast is a timeline maker for work, school, research, and stories.